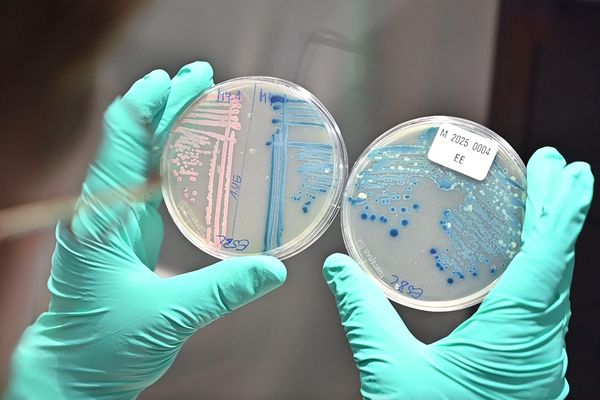
Researcher holds two agar plates

Antimicrobial resistance is still an underestimated problem. Resistant bacteria are by no means only found in hospitals, they also occur in the natural environment. Prof. Katharina Schaufler and her team from the Helmholtz Institute for One Health (HIOH) in Greifswald – a site of the Helmholtz Centre for Infection Research (HZI) – have detected antibiotic-resistant bacteria in surface water at various locations in the Greifswalder Bodden. The sampling sites also included a bathing area, and in some cases, the detected bacteria were even multidrug-resistant. However, these findings do not indicate an acute danger to residents and tourists. Nevertheless, according to Schaufler, the situation should be taken seriously and action should not be delayed until the situation worsens.

The term “silent pandemic” was coined in connection with the problem of antibiotic-resistant bacteria. What does this mean?
Katharina Schaufler: We use the term “silent pandemic” to describe a global, imminent health risk: More and more bacterial pathogens are becoming insensitive to existing antibiotics because they are being used excessively and sometimes incorrectly in human and veterinary medicine as well as in agriculture. Under this selection pressure, resistant strains are on the rise and spreading in hospitals, the community and the environment. Unlike COVID-19, this is not about a single pathogen whose spread is increasing, but about many different – in this case – bacterial pathogens. There is currently no acute crisis like the corona pandemic, but the burden of antibiotic-resistant bacteria is steadily increasing. Without consistent measures, which include the responsible use of antibiotics – i.e. antibiotic stewardship – as well as infection prevention and One Health surveillance, there is a much greater risk of infections that will be difficult to treat in the future.
Can the status quo be backed up with figures? How high is the current risk of people dying from infections as a result of antimicrobial resistance?
For Germany, it was estimated in 2019 that almost 10,000 people died from infections due to antimicrobial resistance. Deaths involving resistance were estimated at just over 45,000. The global estimates for 2019 were 1.27 million and 4.95 million, respectively. These figures show: Mortality associated with antimicrobial resistance is already relevant today.
So far, preventive measures have primarily focused on curbing the – sometimes uncritical and inflationary – use of antibiotics. You are looking at and investigating the problem in a wider context…
Yes, the HIOH has set itself the goal of thinking about health in a broader context. The use of antibiotics in human and veterinary medicine does not take place in a vacuum. We are therefore also interested in ecological aspects. Where and in what quantities are antibiotic-resistant or even multidrug-resistant bacteria detectable in the environment? How do they get there and what negative effects can such environmental pollution have? Are there reservoirs of resistant bacteria in wild animal populations? We are addressing these important questions.
Antimicrobial resistance can spread very quickly under certain circumstances. Perhaps you could briefly explain exactly how this happens?
Antimicrobial resistance is caused by spontaneous mutations, among other things. For example, as a result of a mutation, a bacterium develops the ability to pump antibiotics out of the cell. When such a bacterium divides, it passes on the resistance mechanism to its offspring. This is known as vertical gene transfer. In an environment containing antibiotics, the resistance mutation gives the bacteria in question a selection advantage and they will spread within the population.
In contrast, horizontal gene transfer involves an exchange of genetic material between bacteria of different strains or species. A so-called pilus forms between two bacterial cells, through which ring-shaped pieces of DNA – plasmids – containing genetic information are usually transferred from one cell to the other. Resistance genes can also be exchanged through this mechanism, which is known as conjugation. Other mechanisms of horizontal gene transfer that can significantly accelerate the spread of resistance are transformation and transduction, i.e. the uptake of free DNA or the transfer of DNA by bacteriophages.
Let's come back to your One Health approach. In a study published at the end of 2024, your department investigated the contamination of surface water with multi-resistant microorganisms. What exactly did you want to find out? And how did you go about it?
We wanted to find out whether contamination of surface water with antibiotic-resistant bacteria and antibiotic residues is detectable. To do this, we took samples of surface water at three different locations in the Greifswalder Bodden area: near a sewage treatment plant, at a more distant Baltic Sea beach and in a more shielded area on the island of Riems. We used Escherichia coli as indicator bacteria.
And what did you find out?
We found antibiotic-resistant Escherichia coli at all locations, some of which were multidrug-resistant strains. As expected, the highest numbers were found near the sewage treatment plant, but the water was also contaminated with resistant bacteria in the Baltic Sea bathing area further away and even near the island of Riems.
Were the quantities of bacteria at a level that could be assumed to pose an acute health risk?
No, this is currently not the case. Based on our results and regulatory limits, we do not currently classify the water quality as too critical with regard to antibiotic-resistant bacteria. However, you should not go into the water if you have major wounds or a pronounced immune deficiency, as an infection cannot be ruled out in these cases.
The decisive result of our study is the fact that resistant bacteria can be detected in the environment at all. This means that they have entered the environment from the original source. And something else is important: We found resistant bacteria in the analyzed water samples – regardless of whether antibiotic residues were measurable or not. This suggests that continued direct antibiotic selection pressure is not necessarily required for resistant bacteria to persist in the environment in detectable concentrations.
Should consequences be drawn in view of these results?
A definitive answer is not possible at present. We have first established the status quo. The higher concentrations of multidrug-resistant bacteria in the vicinity of wastewater treatment plants suggest that wastewater treatment should be further optimized. Wastewater treatment plants usually operate with three treatment stages. It needs to be examined whether a fourth treatment stage – for example through ozonation/activated carbon – can additionally and sustainably reduce the bacterial count.
Raising awareness of the problem of antimicrobial resistance is of great importance – this cannot be emphasized often enough. Both political decision-makers and the general public should be informed. This is the only way that prevention can work, and everyone can contribute to this. It is important to reduce the use of antibiotics to the necessary minimum. There is still a considerable need for action in both veterinary and human medicine. A frequently cited example of uncritical use is simple viral respiratory infections, for which antibiotics do not help.
Your working group has already developed science communication concepts to draw attention to the problem of multi-resistant bacteria in nature. Among other things, you were awarded the Undine Award 2025 for this…
The Undine Award 2025 for our project “Habitat Greifswalder Bodden – AMR Research for Health, Environment and Society” is confirmation and motivation for us. The prize, which is awarded by the Josef Wund Foundation for innovative, future-oriented concepts with a view to the vital resource of water, recognizes our approach of incorporating aquatic ecosystems into strategies to combat antimicrobial resistance. It is very important to us to communicate our findings to the general public. This should start as early as possible, which is why we have developed programs for school classes. This involves children and young people actively engaging with the topic in the natural environment. In addition, educational trails for locals and tourists are to be set up in the coastal region next year.
Interview: Ulrike Viegener
Original publication on E. coli in the Baltic Sea
Lübcke P, Heiden SE, Homeier-Bachmann T et al: Multidrug-resistant high-risk clonal Escherichia coli lineages occur along an antibiotic residue gradient in the Baltic Sea. npj Clean Water 7, 94 (2024). https://doi.org/10.1038/s41545-024-00394-7

![[Translate to German:] [Translate to German:]](/fileadmin/HIRI/__processed__/b/9/csm_Jahresrueckblick_2025_963859644e.jpg)











![[Translate to German:] [Translate to German:]](/fileadmin/HIRI/__processed__/e/6/csm_2025_11_20_Neubaufuehrung_fuer_Mitarbeitende_c_HIRI_Yara_Huisl_06_low_0cac9755ff.jpg)






























































![[Translate to German:] [Translate to German:]](/fileadmin/HIRI/__processed__/5/4/csm_2024_10_EUREKA__c_HIRI_Luisa_Macharowsky_3_low_01_863006bd0e.jpg)







































![[Translate to German:]](/fileadmin/HIRI/__processed__/3/3/csm_2022_07_BEISEL_Chase_2_cropped_Low_a7a341cf03.jpg)





































![[Translate to German:] [Translate to German:]](/fileadmin/HIRI/__processed__/2/8/csm_Collage_WUE_9fa1cd516c.jpg)











![[Translate to German:] [Translate to German:]](/fileadmin/HIRI/__processed__/0/8/csm_05_Saliba_02_c_HIRI_Luisa_Macharowsky_ohne_Lacoste_low_zugeschnitten_2_01_9822d73a3f.jpg)






![[Translate to German:] [Translate to German:]](/fileadmin/HIRI/__processed__/c/c/csm_HIRI-Grundstseinlegung_Foto__c_Mario_Schmitt_79ad64af6d.jpg)













![[Translate to German:] [Translate to German:]](/fileadmin/HIRI/__processed__/c/2/csm_2023_04_Smyth_Paper_c_HIRI_Luisa_Macharowsky_2_low_84f993d581.jpg)


































![[Translate to German:] [Translate to German:]](/fileadmin/HIRI/__processed__/e/2/csm_2022_11_HIRI_City_of_Wuerzburg_Child_Care_c_HIRI_Luisa_Macharowsky_2_low_6445b253eb.jpg)
![[Translate to German:] [Translate to German:]](/fileadmin/HIRI/__processed__/3/9/csm_HIRI_key_visual_CHurtig_606d992d74.jpg)





































![[Translate to German:] [Translate to German:]](/fileadmin/HIRI/__processed__/f/0/csm_Ahsen_blue2_6e28a4ee6b.jpg)














![[Translate to Deutsch:] [Translate to Deutsch:]](/fileadmin/HIRI/__processed__/a/5/csm_2022_02_Marco_Olguin_HIRI-Luisa_Macharowsky_04_low_new_3dc837191c.jpg)


![[Translate to Deutsch:] [Translate to Deutsch:]](/fileadmin/HIRI/__processed__/3/c/csm_Joerg_Vogel_Portrait_-_photocredit_Mario_Schmitt__c__HIRI_5013b9643b.jpg)






![[Translate to Deutsch:] [Translate to Deutsch:]](/fileadmin/HIRI/__processed__/a/6/csm_RNA_Delivery_1902376336.jpg)
![[Translate to Deutsch:]](/fileadmin/HIRI/__processed__/7/c/csm_Caliskan_Kibe_Pekarek_105c7d1860.jpg)
![[Translate to Deutsch:] [Translate to Deutsch:]](/fileadmin/HIRI/__processed__/c/1/csm_N-Caliskan_M-Zimmer_Zoom_c93c493293.jpg)













































